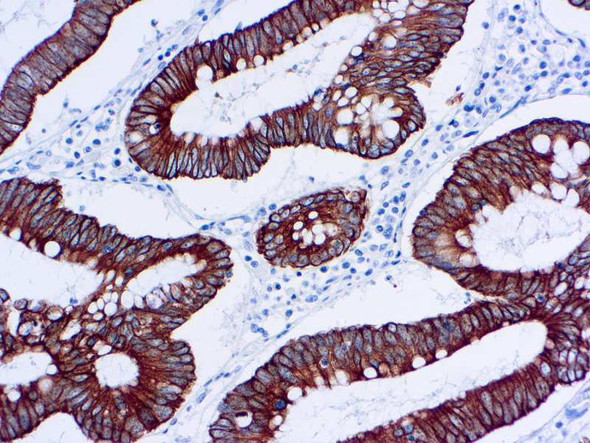
CK5 Cytokeratin 5, Clone XM26
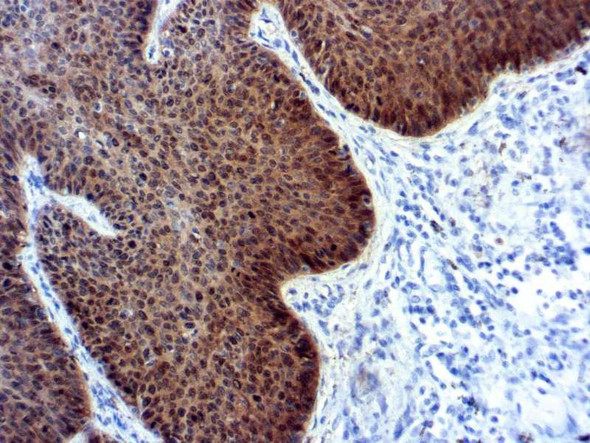
p16 (RUO) Concentrate

- Product
- Qty in Cart
- Quantity
- Price
- Subtotal
-

Antibodies
Cytokeratin 5/6, Clone D5/16B4, (Manual Use)
Mouse Monoclonal. Intended for in vitro diagnostic (IVD) use. Cytokeratin 5 and cytokeratin 6 are both high-molecular weight, basic keratins expressed in a range of normal tissues. CK 5/6 are positively seen in nearly 100% of malignant mesotheliomas and... -

Antibodies
PSAP, Clone PASE/4LJ, 10mL
Mouse Monoclonal. Ready-to-use. Intended for in vitro diagnostic (IVD) use. This antibody is specific to human prostatic acid phosphatase. It reacts with the glandular epithelium of normal and hyperplastic prostate and with prostate adenocarcinoma. PSAP... -

Antibodies
Mast Cell Tryptase, Clone AA1
Mast Cell Tryptase, Clone AA1, 10ml, Mouse Monoclonal, Intended for in vitro diagnostic (IVD) use. -

Antibodies
CD45 LCA, Clone 2B11+PD7/26, 10mL
Mouse Monoclonal, RTU. Intended for in vitro diagnostic (IVD) use. CD45(LCA) antigen is a family of five or more high molecular weight glycoproteins of MW 180, 190, 205 and 220 kDa, present on the surface of the majority of human leukocytes. This... -
-

Antibodies
MART-1/Melan A, Clone A103 (MM97-GROUPED)
Mouse Monoclonal, RTU. Intended for in vitro diagnostic (IVD) use. MART-1(Melan-A) is a transmembrane protein present in melanocytes of normal skin, retina, nevi, and most melanomas. This antibody is useful in the classification of metastatic melanomas,... -

Antibodies
Androgen Receptor (AR), Clone AR 441
Mouse Monoclonal. Intended for in vitro diagnostic (IVD) use. This antibody is specific to a protein of 110 kDa, identified as androgen receptor. It reacts with full length AR and also with the newly described A form of the receptor. The antibody does... -

-

-

Antibodies
DOG-1, Clone DOG1.1, 10ml
DOG-1, Clone DOG1.1, 10ml, Mouse Monoclonal, RTU. Intended for in vitro diagnostic (IVD) use. -

Antibodies
p40(P) Clone ZR8, 10mL
Rabbit Polyclonal, RTU. Intended for in vitro diagnostic (IVD) use. p40 is an antibody that recognizes ∆Np63-a p63 isoform and it is highly specific for squamous/basal cells. It may be a valuable marker in detecting Squamous Cell Carcinoma where p63 is... -